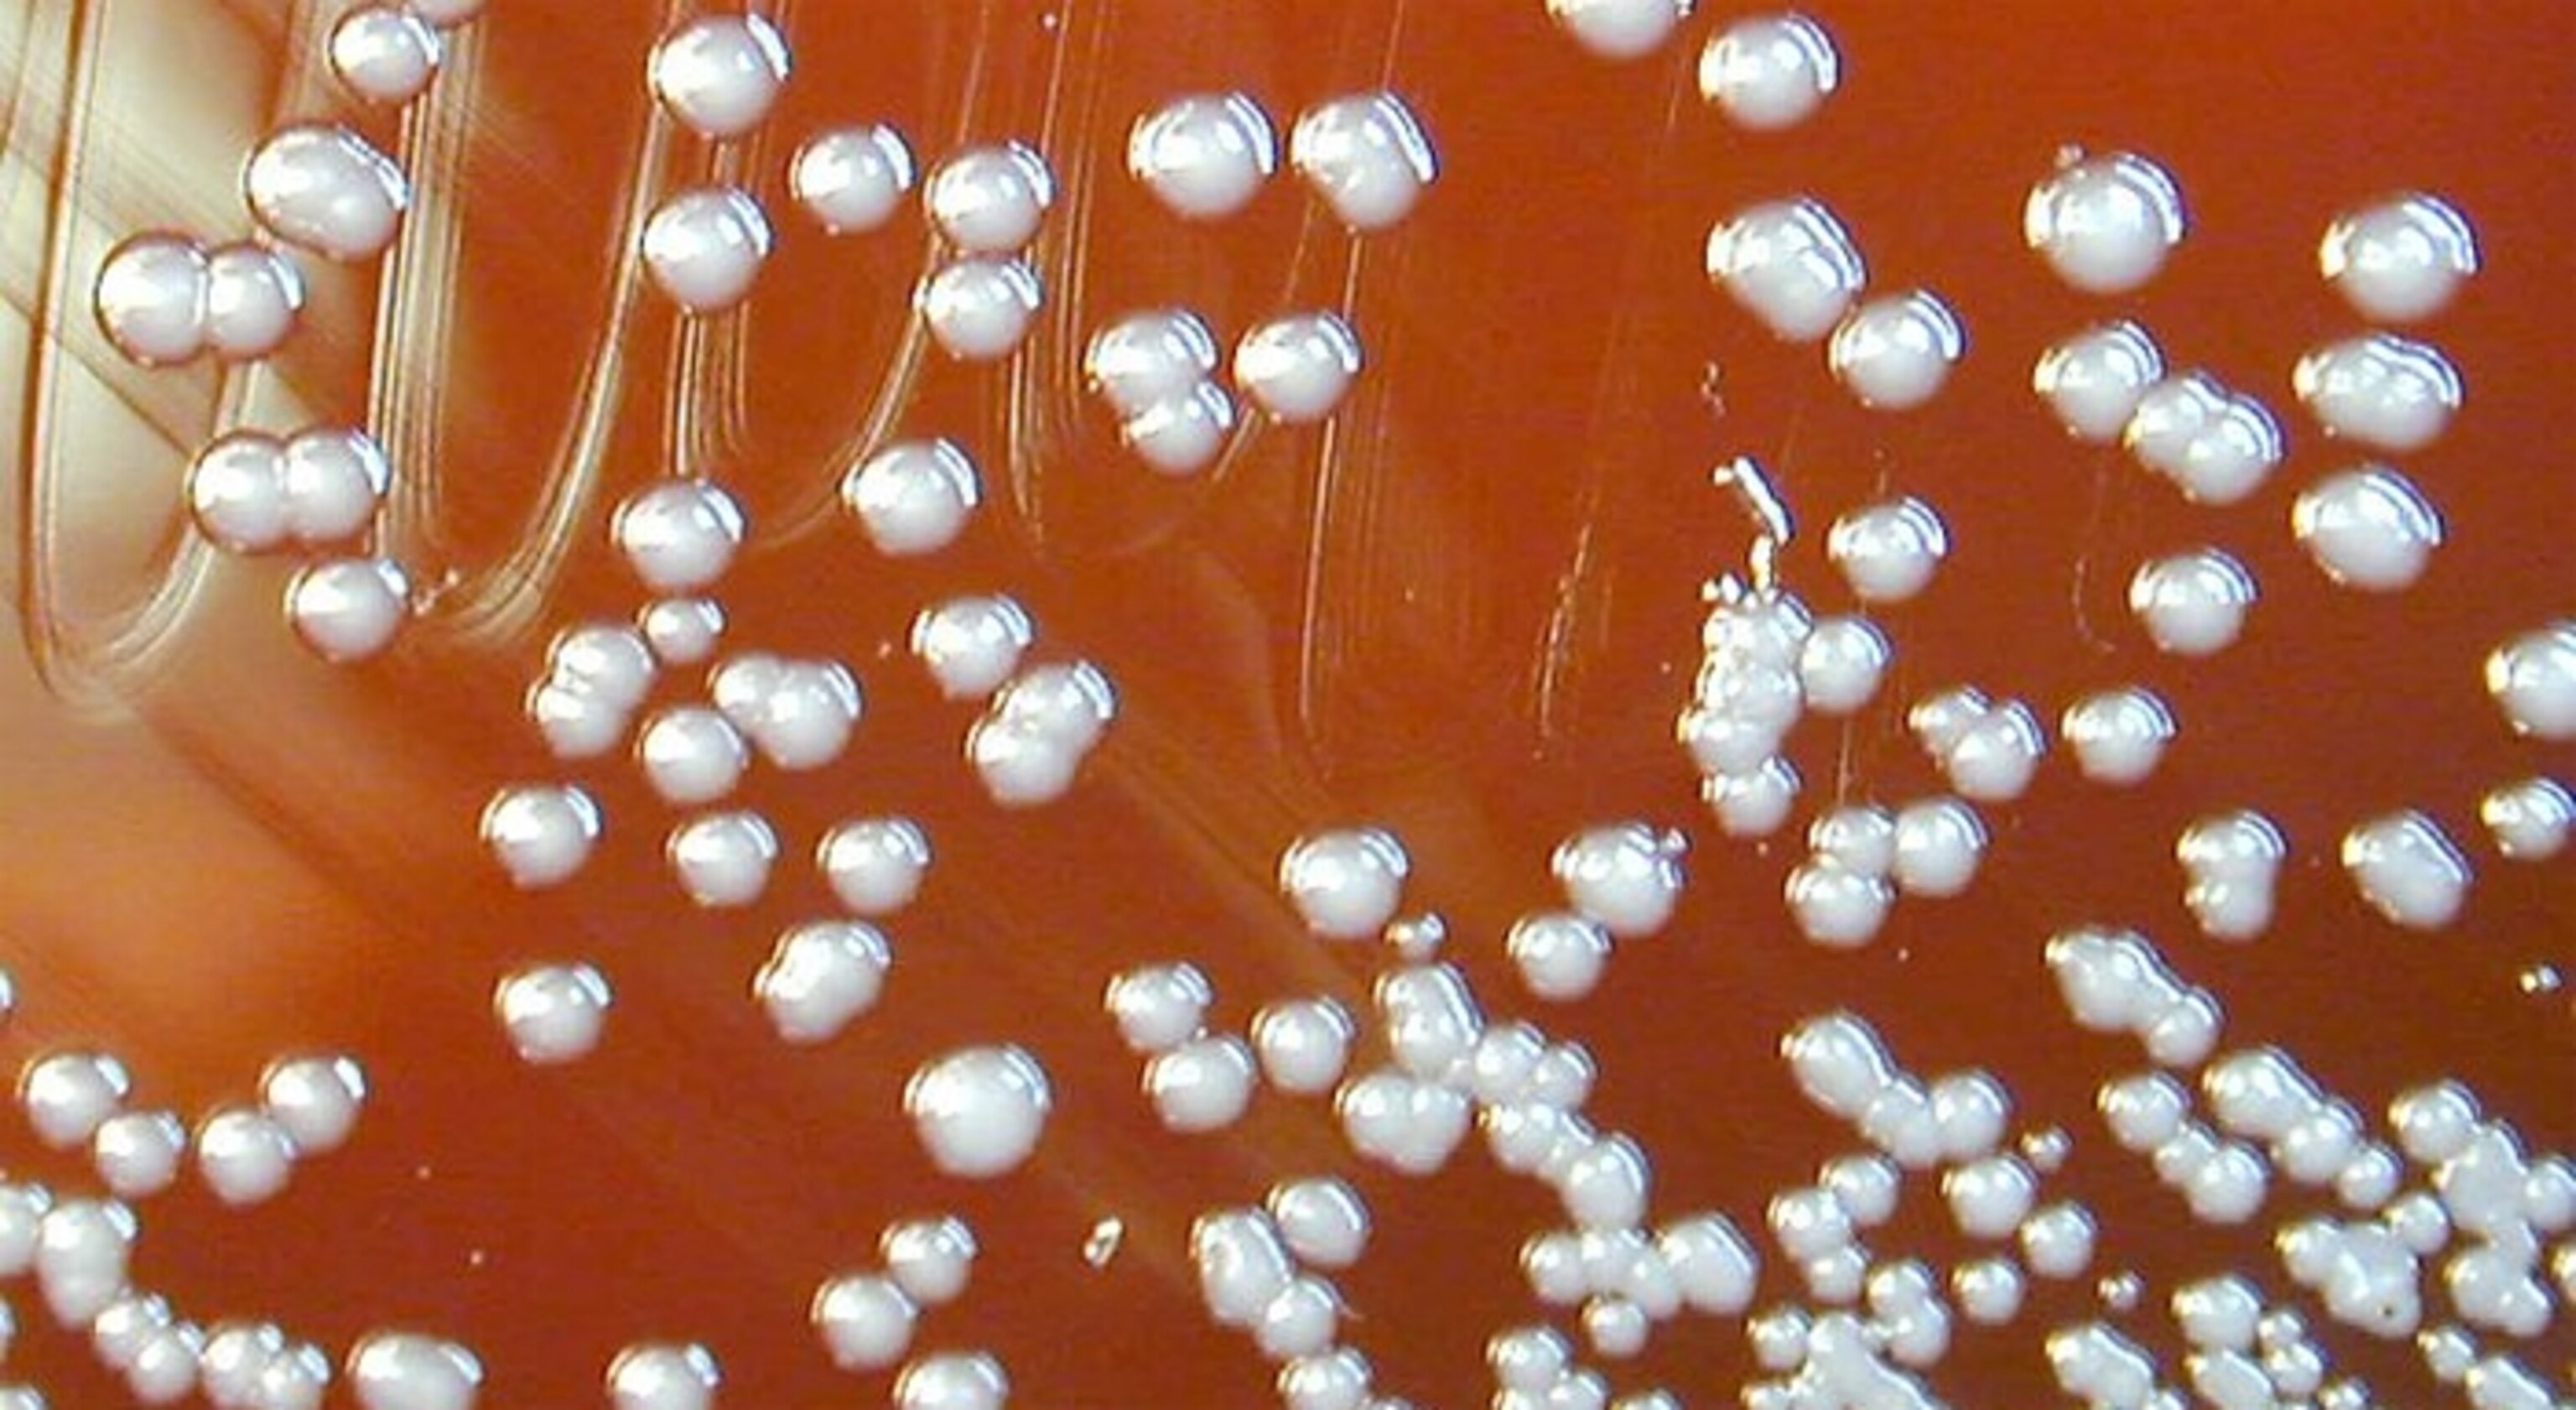

Frequent-Flier Microbes Ride Hurricanes and Live in Clouds

On August 17, 2010, Terry Lathem flew through a hurricane to pick up some bacteria. He had a huge smile on his face. “It was the longest, most thrilling seven hour flight of my life,” he says. “Each passing hour provided new bursts of adrenaline as the storm intensified, lightning flashed in the distance, and heavy rain streamed across the windows.”
A month later, he was at it again.
On both occasions, he flew aboard an old DC-8 plane, which had been retrofitted into a flying laboratory. With him was a team of NASA scientists, who were taking part in the agency’s ambitious GRIP experiment—a mission to study how hurricanes are born. They hit two hurricanes in six weeks—Earl and Karl.
Aside from taking environmental reading, the flights were also surgical operations. Their mission: to biopsy the storms. As they criss-crossed Earl and Karl, they sucked in the surrounding air into sampling tubes. These filtered out big droplets or ice crystals and retained everything else—gases, dust, minerals… and bacteria. That was what Lathem was out to find. And he found them in their thousands.
Back on the ground, he analysed the hard-won samples with Natasha DeLeon-Rodriguez, a fellow student from the Georgia Institute of Technology. Together, they have provided a world’s first: an inventory of the invisible life of the upper troposphere—the zone that sits 8 to 15 kilometres above the Earth’s surface. Even here, with little oxygen, freezing temperatures and intense bombardments of solar radiation, there is life. Microbes float through the air above the ocean surface at altitudes that even Everest cannot pierce.
Maybe they’re breaking down the airborne chemicals they find there, literally eating the clouds. Maybe they’re seeding the creation of the clouds in the first place, by acting as chewy biological centres around which crunchy ice crystals can form. The team will need to test these possibilities, but one thing is already clear: These cells are alive. They’re not the carcasses of microbes blown up on the wind—they’re living residents of perhaps the most uncharted habitat on the planet. And a few of these consistent cloud-riders are everywhere.

Up, up and away
The word “microbiome” was originally coined to refer to all the microbes on the human body, and the genes within them. But the term can really apply to any environment where microbes abound… which is all of them. There’s a soil microbiome. A panda microbiome. A hospital microbiome.
The sky has a microbiome too, and one that may have a critical role in the creation of weather. When water changes from vapour to liquid, it condenses around microscopic particles in the air. When it freezes into ice, the same thing happens. Without these centres, completely pure water would condense and freeze at much lower temperatures than you’d expect. Dust, soot and sea salt can all act as nuclei for water’s transformations, but so can bacteria. For example, some plant-infecting species have proteins on their surfaces that ice can crystallise upon. Just by floating in the air, species like these could kick-start the births of clouds, raindrops and snow.
Scientists have collected samples of microbes that fall to Earth, as snow, rain and hail, and that float in the skies above human settlements, coasts, the Amazon river, and mountaintops. But many parts of the world are still uncharted. But “nobody had sampled the high atmosphere above the oceans,” says Kostas Konstantinidis, who is DeLeon-Rodriguez’s supervisor. “We found quite a few cells up there, more than predicted.”
The team took samples not just from the two Atlantic hurricanes but from clouds around them, and from clear skies over the Atlantic, the coast of California, and the continental US. On average, the samples contained anywhere from 5,000 to 150,000 microbial cells in every cubic metre.
The same volume of soil or seawater would contain tens or hundreds of millions of microbes, and it’s hardly surprising that the airborne communities are sparser. But up there, the living cells account for around 20 percent of all microscopic particles—a far greater proportion than they’d make up elsewhere.
These microbes came mostly from oceans, but also rivers and soils. Some of them were fungi but the vast majority were bacteria. And most of them—upwards of 60 percent—were still alive. “Many people might have guessed that they’re dead cells and spores and we found many cells that are viable,” says Konstantinidis.
Roll-call
The communities were relatively narrow, and the team identified around 314 bacterial species across all their samples. “Apparently not everybody can make it up there,” says Konstantinidis.
Hurricanes certainly help. They picked up huge volumes of bacteria, including species that aren’t normally found in the skies, and carry them up, up and away. These include Escherichia and Streptococcus, which are typically found in the faeces and guts of animals, and can sometimes cause disease. These storms could be acting as huge conveyors belts that carry microbes around the world. “It just opens more questions about how many bacteria might survive this rough atmospheric treatment and continue the ubiquitous spread of organisms around the planet’s surface,” says Jack Gilbert, who is leading the Earth Microbiome Project,
But there are also more consistent residents of the skies. In the team’s samples, 17 species seemed to be everywhere. They weren’t just temporary drifters, launched skywards by storms. They were found over the Pacific and the Atlantic, and clear, cloudy and stormy skies. This consistent cadre of frequent fliers seem to have the right adaptations for surviving in the skies, and can stay aloft for days or weeks.
What’s so special about this core 17, and how do they survive? “We’ll answer in the next five years,” says Konstantinidis. So far, the team have only studied analysed a single gene—rRNA. It’s great for pulling up a roll-call of species from a morass of genetic material, but it doesn’t tell you what this community can do. To find out, the team will sequence the entire genomes of the microbes they found. Perhaps they’ll find genes that help the bacteria to deal with the DNA-shattering effects of ultraviolet radiation, or genes that help them cope with dessication.

Making clouds, eating clouds
Maybe these species help to create clouds and precipitation? They certainly belong to groups that are known to be effective centres for condensation and freezing, but the team needs to actually test their ability to create ice and rain. They will place them in artificial cloud chambers, providing them with the right cocktail of compounds and watching what happens.
Such experiments might also tell us if the bacteria survive by breaking down the chemical constituents of clouds, and driving the chemistry of the skies as they do in every other environment on the planet. Certainly, there’s plenty of water around. And two of the bacterial families that appeared in every sample contain members that are meant to break down oxalic acid, one of the most common chemicals found in clouds.
It’s conceivable that, with water and food around, these microbes could be actively growing. The team admits that they need to test this and Anne-Marie Delort, an atmospheric chemist from the CNRS, agrees. In her experiments, atmospheric bacteria do consume the compounds in clouds… but not oxalic acid.
“If you work in a lab, with bacteria from real cloud samples, they do degrade a number of compounds in clouds,” says Delort. “But there’s a big gap.” Clouds are more complex than anything that scientists can reproduce on their lab benches. They look white and fluffy, but they’re really swirling masses of condensation and evaporation, changing temperatures, and other assorted physical turmoil.
To really understand what’s going on inside, and how the microbes are contributing, Delort says that we need models that combine physics, chemistry and biology. That’s difficult, since most scientists who study the atmosphere are more focused on the physics than the role of living things, and those working on the microbes lack expertise in the physical sciences. “I think we’re at the very beginning,” says Delort. “The topic is very new.”
Reference: DeLeon-Rodriguez, Lathem, Rodriguez-Ra, Barazesh, Anderson, Beyersdorf, Ziemba, Bergin, Nenes & Konstantinidis. 2013. Microbiome of the upper troposphere: Species composition and prevalence, effects of tropical storms, and atmospheric implications. PNAS http://dx.doi.org/10.1073/pnas.1212089110
More bacteria in extreme places:
- Bacteria unite to form living electric cables
- Isolated for millions of years, cave bacteria resist modern antibiotics
- Oil-eating bacteria have started to clean the Deepwater Horizon spill
- Genes from Arctic bacteria used to create new vaccines
- Blood Falls – bacteria thrive for millions of years beneath a rusty Antarctic glacier
- An ecosystem of one in the depths of a gold mine
- Snow-making bacteria are everywhere